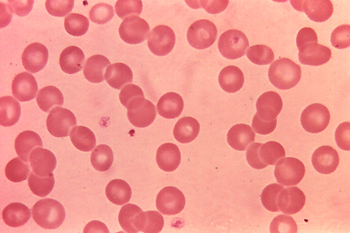
Rouleax formation

| Rouleaux formation
-
The RBCs stack on one
another like a roll of coins.
-
Roll the cursor over the image
if you don't see this.
-
Something has changed the
RBC's surface charge.
-
They are normally negatively
charged so they will repel each other and prevent changes such we see above.
|